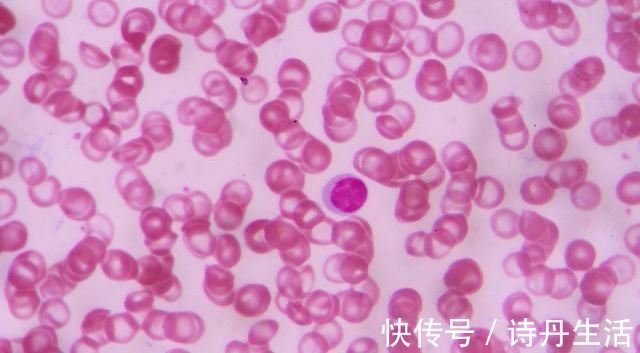
信号|身体催你戒酒的3种信号,若你全占了,或许就要考虑戒酒了!

信号|身体催你戒酒的3种信号,若你全占了,或许就要考虑戒酒了!
不知道大家在生活当中有没有听过这样的话,酒是粮食精,越喝越年轻,所以说不管是在平时的工作应酬还是亲朋好友聚会中,人们都喜欢喝一些小酒,还有一句话说的好,小酌怡情,大饮伤身,如果喝太多的酒,很容易给自身的体质带来一定的影响和伤害,特别是影响到肝脏器官的正常运转,由于人们的肝脏器官是没有神经末梢的,出现不舒服的情况也不会发出疼痛但是却会伤害到身体,而且还出现异常变化,所以说人们在生活当中一定要了解身体健康以及身体出现的变化,如果身体村里借久了会出现这3种信号,不妨一起来了解一下吧。

文章插图
身体催你戒酒的3种信号,若你全占了,或许就要考虑戒酒了!
1、血压异常
其实在现在的社会生活当中,大部分的人都觉得喝酒与高血压有着一定的关系,这主要是由于人们往往在喝完酒之后会发现身体的血压值出现升高的现象,而且血管也会非常的扩张导致血压出现升高或者是降低,其实出现这样的情况很容易给身体造成一定的伤害,严重的时候出现头晕,如果人们发现喝完酒之后自己的血压值升高,那么一定不要再继续喝酒了,只有把酒戒了自己的身体才会更加健康。

文章插图
2、身体某些部位莫名出血
如果人们身体当中的某一个部位出现出血,其实这也是不正常的,很可能是由于身体出现了疾病而引起的,特别是人们的牙医或者是鼻子出血,这也是疾病的信号,有可能是由于喝酒而造成的,比如说经常喝酒出现酒精肝,脂肪肝严重的时候出现肝癌,酒精肝对于人们身体当中的血小板生成有着一定的减少作用,如果人们出现莫名其妙的出血,或者是身体出现了这种问题,抓紧去医院进行检查,可千万不要忽略了。
【 信号|身体催你戒酒的3种信号,若你全占了,或许就要考虑戒酒了!】
文章插图
3、脸色发黄
如果人们发现喝完酒之后脸色特别的发黄,其实脸色发黄,主要是由于肝脏器官的排毒解毒功能出现了一定的异常而导致的肝脏器官没有将身体当中的毒素和垃圾及时排出身体之外,就会出现这种情况,如果人们再次喝酒就会导致病情加重,严重的时候出现肝硬化,所以说身体出现这些情况可千万不要忽略了,及时解决才是最关键的。

文章插图
各位朋友们!这3个表现都了解了么?对此文章你还有更好的意见和看法吗?欢迎大家到小编文章评论去留言评论,喜欢小编的文章可以关注小编的账号,小编会每天不定时的为大家推出健康养生知识,与大家一起分享。
- 肌肤|女性不愿老太快,坚持多吃3种食物,滋补身体,好处多多!
- 口味|给孩子做个“快手菜” 营养丰富,口味独特,提高身体的免疫力
- 零下度|冬季天气寒冷身体变虚弱了,多吃家常菜,补血养肝有利健康
- 代谢|运动代谢图谱揭示何时运动最好
- 丝瓜|常吃丝瓜对身体好,但丝瓜不能与一物同吃,爱吃的人得忌口了!
- 肝细胞|想长寿先养肝,多吃三种蔬菜,养肝护肝,滋补身体,脸色更红润
- 肾功能|与尿蛋白升高有关的5个信号是尿毒症的前兆,肾友要当心
- 孩子春节最爱“黄金菜”,补充营养,增强免疫力,身体更健康!
- 虎年到来努力工作,多吃3种平安果,寓意身体安康
- 人们身体缺乏营养脸上一点气色都没有,多吃家常菜,补血养肝
